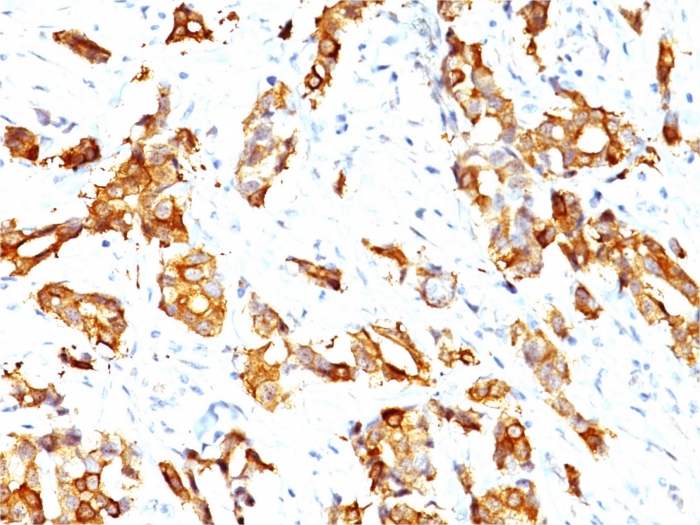

Formalin-fixed, paraffin-embedded human breast carcinoma stained with HSP27 Mouse Monoclonal Antibody (SPM252).
Formalin-fixed, paraffin-embedded human breast carcinoma stained with HSP27 Mouse Monoclonal Antibody (SPM252).

SDS-PAGE Analysis Purified HSP27 Mouse Monoclonal Antibody (SPM252). Confirmation of Integrity and Purity of Antibody.
It recognizes a 24-27kDa estrogen-regulated protein, identified as heat shock protein 27 (hsp27). Hsp27 was recently found to be identical to the estrogen-induced p29 and 24K protein. About 50% of breast carcinomas are positive for hsp27 especially those that are also positive for estrogen and/or progesterone receptor. HSP27 has also been implicated in drug resistance in cancer cells.
There are no reviews yet.